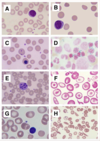
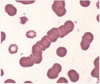

tarry-sky pattern is seen in which one of the following lymphomas?
- A ) Anaplastic large cell lymphoma
- B ) Burkitt’s lymphoma
- C ) Diffuse large B-cell lymphoma
- D ) Hairy cell leukemia
- E ) Nodular sclerosing classical HL

= B ) Burkitt’s lymphoma
A 56-year-old man was admitted with sudden onset severe hypotension, widespread urticaria, and angioedema following a wasp sting. Anaphylaxis was suspected and treated appropriately according to the Resuscitation Council guidance. One of the nurses took some extra blood while inserting a spare cannula during resuscitation and asks you if you want any tests done.
Which blood test should be taken as soon as possible during the management of acute anaphylaxis?
- A ) Mast-cell tryptase
- B ) Serum histamine
- C ) Specific IgE
- D ) Specific IgG
- E ) Total IgE
= A ) Mast-cell tryptase

Investigation of a suspected anaphylactic reaction requires measurement of ___ levels.
- A ) Histamine
- B ) IL13
- C ) IL4
- D ) Tryptase
- E ) Tyrosine
= D ) Tryptase
Mast-cell tryptase blood tests should be taken immediately, 1-2 hours post event and 24 hours post event. Prolonged observation is not required in patients that have recovered completely, but they should be advised of the possibility of a biphasic reaction.
What disease is mediated by type II hypersensitivity?
- A ) Allergy (atopic form)
- B ) Anaphylaxis due to penicillin
- C ) Autoimmune hemolytic anaemia
- D ) Contact dermatitis
- E ) MS
- F ) Rheumatoid arthritis
- G ) Systemic lupus erythematosus
Answer: Autoimmune hemolytic anaemia

The ‘wheal and flare’ reaction is seen in which type of hypersensitivity reaction?
- A ) Type I
- B ) Type I and II
- C ) Type II
- D ) Type III
- E ) Type IV
= A ) Type I

IgA antibody is the first line of defence against infections at the mucous membrane. It is usually an early specific antibody.
Which of the following statements regarding IgA is true?
- A ) Complement fixation test is useful for IgA antibody
- B ) IgA can not be destroyed by bacterial proteases
- C ) IgA is a small molecule with a molecular weight of 30,000 kDa
- D ) IgA is not found in saliva, therefore an IgA diagnostic test on saliva would have no value
- E ) IgA is present in colostrum
Answer: IgA is present in colostrum
Each secretory IgA molecule has a molecular weight of 400,000 and consists of two H2L2 units and one molecule each of J chain and secretory component. Some IgA exists in serum as a monomer H2L2 with a molecular weight of 160,000. Some bacteria, such as Neisseria, can destroy IgA1 by producing protease. It is the major immunoglobulin in milk, saliva, tears, and colostrum. IgA does not fix complement, so one would anticipate that a complement fixation test would not be useful for IgA antibody.
Individuals with allergic rhinitis who are exposed to an allergen will within minutes experience symptoms of nasal itching, nasal congestion, sneezing, and a runny nose. These symptoms generally subside within 30 minutes, but reappear several hours later. Analysis of the nasal epithelium in such an individual 6 hours after allergen encounter would show:
- A ) An influx of commensal microbes due to breaches in the epithelial barrier
- B ) High concentrations of IL-22 important in repair of the damaged epithelium
- C ) Infiltration of eosinophils, basophils, neutrophils, T cells, and macrophages
- D ) The absence of allergen-specific IgE on mast cells in the tissue
- E ) Very low levels of histamine and other inflammatory mediators
= C ) Infiltration of eosinophils, basophils, neutrophils, T cells, and macrophages
Which type of ultraviolet light causes most skin cancers?
- A ) UVA
- B ) UVB
- C ) UVC
- D ) UVD
- E ) UVE
= B ) UVB
UVC is the most dangerous ultraviolet wavelength but is mostly absorbed in the ozone layer.
Immunity may be natural or acquired. Which of the following best describes acquired immunity?
- A ) Complement cascade
- B ) Increase in C-reactive protein (CRP)
- C ) Inflammatory response
- D ) Maternal transfer of antibody
- E ) Presence of natural killer (NK) cells
= D ) Maternal transfer of antibody
Natural immunity is nonspecific. The description of natural immune functions described are not specific for a certain antigen. For example, certain proteins such as C-reactive protein (CRP) are acute-phase reactants. While elevated CRP is seen in infection, it is not disease-specific. Maternal transfer of antibody, however, is passive but still confers specific immunity. It is termed acquired immunity.
What disease is mediated by type IV hypersensitivity?
- A ) Autoimmune hemolytic anaemia
- B ) Goodpasture’s syndrome
- C ) Hemolytic disease of the newborn
- D ) MS
- E ) Post streptococcal glomerulonephritis
- F ) Rheumatoid arthritis
- G ) Systemic lupus erythematosus
= D ) MS

Which immunoglobulin class is found on the surface of mast cells?
- A ) IgA
- B ) IgD
- C ) IgE
- D ) IgG
- E ) IgM
= C ) IgE
What is a highly variable autoimmune disease mediated by type III hypersensitivity?
- A ) Allergic contact dermatitis
- B ) Diabetes type I
- C ) Goodpasture’s syndrome
- D ) Graft rejection
- E ) Hemolytic disease of the newborn
- F ) Multiple sclerosis
- G ) Rheumatoid arthritis
= G ) Rheumatoid arthritis

Which immunoglobulin class is a major component of mucosal secretions?
- A ) IgA
- B ) IgD
- C ) IgE
- D ) IgG
- E ) IgM
Answer: IgA
The major immunoglobulin class in normal adult human serum is:
- A ) IgA
- B ) IgD
- C ) IgE
- D ) IgG
- E ) IgM
Answer: IgG
Individuals with peanut allergies can exhibit a variety of symptoms following exposure to the peanut allergen. These symptoms can include a runny nose; skin reactions such as hives; itching in the mouth and throat; digestive problems such as cramps, diarrhea or vomiting; and respiratory problems such as wheezing and shortness of breath. This variety of symptoms is the result of:
- A ) Systemic production of inflammatory mediators causing responses in many tissues
- B ) The high concentrations of histamine present in pre-stored mast cell granules
- C ) The presence of high concentrations of monomeric IgE in the circulation
- D ) The presence of mast cells with pre-bound IgE in all mucosal tissues
- E ) The simultaneous exposure of skin, oral mucosa, throat, and gastrointestinal tract to an ingested allergen
Answer: The presence of mast cells with pre-bound IgE in all mucosal tissues
Unlike other antibody isotypes, IgE is found almost exclusively bound to the surface of mast cells and basophils. Mast cells are present in all mucosal tissues and, if pre-bound to allergen-specific IgE, encounter with the allergen will trigger mast cell activation and degranulation. Depending on the levels of allergen, the amounts of allergen-specific IgE, and the route of allergen entry, different individuals can exhibit some or all of these allergic symptoms.
Immune privileged sites, such as the brain, the eye, and the testis, are often the targets of autoimmune attack. Thus, once effector T cells are generated that have specificity for autoantigens expressed in these tissues, the effector cells can gain entry to the tissue and cause tissue damage. However, under normal circumstances, the priming and differentiation of effector cells specific for antigens found in the brain, for example, is generally prevented. This is because ‘immune privileged’ sites:
- A ) Are surrounded by tissue barriers that block all lymphocyte trafficking
- B ) Express antigens that never leave the tissue where they are produced
- C ) Express the cell death receptor, Fas
- D ) Express the cytokine, TGF-β
- E ) Promote the differentiation of TH17 cells
Answer: Express the cytokine, TGF-β

A 32-year-old male is found to have recurrent haematuria since his youth. The haematuria typically occurs with upper respiratory tract infections, especially sore throats. Vital signs are normal. Urinalysis shows proteinuria, haematuria and a few red blood cell casts. Laboratory studies disclose normal levels of urea and creatinine and tests for antinuclear antibody and antineutrophil cytoplasmic antibody are negative.
What is the likely diagnosis?
- A ) Amyloid nephropathy
- B ) Hereditary nephritis (Alport syndrome)
- C ) IgA nephropathy
- D ) Membranous glomerulopathy
- E ) Wegener granulomatosis
= C ) IgA nephropathy
Type I hypersensitivity reactions are mediated by which immunoglobulin?
- A ) IgA
- B ) IgD
- C ) IgE
- D ) IgG
- E ) IgM
= C ) IgE

Which of the following is true regarding the combined oral contraceptive pill?
- A ) An active pill is taken for 21 days and then a sugar pill is taken for 7 days
- B ) It contains progesterone only
- C ) It increases the pulse frequency of GnRH
- D ) It increases the secretion of LH by the anterior pituitary
- E ) It is not useful in menorrhagia
Answer: An active pill is taken for 21 days and then a sugar pill is taken for 7 days
- The predominant antibody found in a primary immune response is:
- A ) IgA
- B ) IgD
- C ) IgE
- D ) IgG
- E ) IgM
= E ) IgM
A newborn infected with group B streptococcus would produce and secrete antibody of which of the following class(es)?
- A ) IgA
- B ) IgD
- C ) IgE
- D ) IgG
- E ) IgM
= E ) IgM
A normal newborn can make IgM antibody in response to challenge with antigen. If IgG is detected in the newborn, it is most likely the result of placental transfer from the mother.
Which immunoglobulin class can cross the placenta?
- A ) IgA
- B ) IgD
- C ) IgE
- D ) IgG
- E ) IgM
Answer: IgG
In individuals with a peanut allergy, a mild allergic response is defined those that involve a only single site, typically a skin reaction (such as hives). More severe allergic reactions generally involve multiple tissue sites, such as the skin, oral mucosa, airway mucosa, and gastrointestinal tract. Given the two groups of allergic patients, one with only skin responses, and the other with 3–4 different tissue sites involved, one would expect that:
- A ) Patients with mild allergic responses would have fewer mast cells in the majority of their mucosal tissues.
- B ) Patients with mild allergic responses would have higher numbers of CD4+ T regulatory cells.
- C ) Patients with severe allergic responses would also have allergies to several other substances, such as bee venom or pollen.
- D ) Patients with severe allergic responses would have reduced expression of antioxidant enzymes, such as glutathione-S-transferases
- E ) Patients with the severe allergic responses would have higher concentrations of allergen-specific IgE.
Answer: Patients with the severe allergic responses would have higher concentrations of allergen-specific IgE.
A child stung by a bee experiences respiratory distress within minutes, and lapses into unconsciousness. This reaction is probably mediated by:
- A ) IgA
- B ) IgD
- C ) IgE
- D ) IgG
- E ) IgM
= C ) IgE